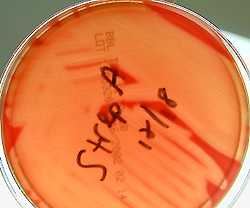

Mr. PF's throat gram stain and
culture.
- How about those gram positive
end-to-end diplococci.
- See the capsule?
- This gram stain is consistent with
streptococcus.
- This is one of the four 'pyogenic'
bugs.
- streptococcus
- staphylococcus
- gonococcus
- meningococcus
|
 |
- Note the beta-hemolysis on sheep
blood agar.
- In other words, complete clearing.
- This is a group A, beta-hemolytic strep.
- It's the protein in the
capsule that may become a problem.
- The antibodies
against the 'M' protein may cross-react with
Mr. PF's tissues.
|
 |
|
|
|